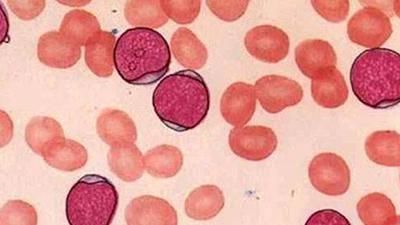
弱激光体外血液净化防止高血压患者年轻化,为

家庭医生在线健康宝典(baodian.familydoctor.com.cn)是中国最专业的健康热点资讯答疑平台,问题涵盖面广,最新的“血液垃圾清理骗局”相关资讯。最专业的“血液垃圾清理

激光净血清除血液垃圾战胜心脑血管病
495x303 - 67KB - JPEG

清除血液垃圾易家通血易通激光价格|清除血液
489x362 - 34KB - JPEG

激光去除红血丝效果,激光去红血丝注意事项
416x448 - 21KB - JPEG

激光治疗仪供应商\/生产供应血液清理激光治疗
358x349 - 16KB - JPEG

【图】激光去除纹身疤痕 干净无痕地还你一个
400x400 - 16KB - JPEG

【图】激光去除纹身疤痕 干净无痕地还你一个
415x400 - 21KB - JPEG

【图】【我爱画眉毛】 怎样去除绣过的眉毛颜
533x800 - 29KB - JPEG

激光去除眼袋效果好不好_祛眼袋 _二炮总医院
290x266 - 16KB - JPEG

弱激光体外血液净化帮您远离睡眠不足引起的视
400x313 - 14KB - JPEG

激光去除黑眼圈手术有哪些副作用
300x400 - 57KB - JPEG
弱激光体外血液净化防止高血压患者年轻化,为
400x247 - 13KB - JPEG

【图】【我爱画眉毛】 怎样去除绣过的眉毛颜
800x773 - 39KB - JPEG
弱激光体外血液净化防止高血压患者年轻化,为
400x225 - 15KB - JPEG

弱激光体外血液净化帮您睡个安稳觉,帮您调节
400x269 - 12KB - JPEG

模型发布。心脏手术。在冠状动脉搭桥和激光心
1280x874 - 227KB - JPEG